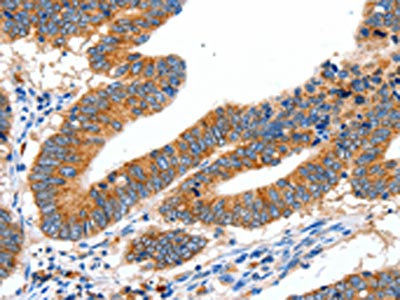

SLC2A1 Antibody
-
中文名稱(chēng):SLC2A1兔多克隆抗體
-
貨號(hào):CSB-PA547464
-
規(guī)格:¥1100
-
圖片:
-
The image on the left is immunohistochemistry of paraffin-embedded Human colon cancer tissue using CSB-PA547464(SLC2A1 Antibody) at dilution 1/40, on the right is treated with synthetic peptide. (Original magnification: ×200)
-
The image on the left is immunohistochemistry of paraffin-embedded Human ovarian cancer tissue using CSB-PA547464(SLC2A1 Antibody) at dilution 1/40, on the right is treated with synthetic peptide. (Original magnification: ×200)
-
Gel: 10%SDS-PAGE, Lysate: 40 μg, Lane: Human seminoma tissue, Primary antibody: CSB-PA547464(SLC2A1 Antibody) at dilution 1/650, Secondary antibody: Goat anti rabbit IgG at 1/8000 dilution, Exposure time: 10 minutes
-
-
其他:
產(chǎn)品詳情
-
Uniprot No.:
-
基因名:
-
別名:Choreoathetosis/spasticity episodic (paroxysmal choreoathetosis/spasticity) antibody; CSE antibody; DYT17 antibody; DYT18 antibody; DYT9 antibody; EIG12 antibody; erythrocyte/brain antibody; Erythrocyte/hepatoma glucose transporter antibody; facilitated glucose transporter member 1 antibody; Glucose transporter 1 antibody; Glucose transporter type 1 antibody; Glucose transporter type 1, erythrocyte/brain antibody; GLUT antibody; GLUT-1 antibody; GLUT1 antibody; GLUT1DS antibody; GLUTB antibody; GT1 antibody; GTG1 antibody; Gtg3 antibody; GTR1_HUMAN antibody; HepG2 glucose transporter antibody; HTLVR antibody; Human T cell leukemia virus (I and II) receptor antibody; MGC141895 antibody; MGC141896 antibody; PED antibody; RATGTG1 antibody; Receptor for HTLV 1 and HTLV 2 antibody; SLC2A1 antibody; Solute carrier family 2 (facilitated glucose transporter), member 1 antibody; Solute carrier family 2 antibody; Solute carrier family 2, facilitated glucose transporter member 1 antibody
-
宿主:Rabbit
-
反應(yīng)種屬:Human,Mouse,Rat
-
免疫原:Synthetic peptide of Human SLC2A1
-
免疫原種屬:Homo sapiens (Human)
-
標(biāo)記方式:Non-conjugated
-
抗體亞型:IgG
-
純化方式:Antigen affinity purification
-
濃度:It differs from different batches. Please contact us to confirm it.
-
保存緩沖液:-20°C, pH7.4 PBS, 0.05% NaN3, 40% Glycerol
-
產(chǎn)品提供形式:Liquid
-
應(yīng)用范圍:ELISA,WB,IHC
-
推薦稀釋比:
Application Recommended Dilution ELISA 1:2000-1:5000 WB 1:500-1:2000 IHC 1:25-1:100 -
Protocols:
-
儲(chǔ)存條件:Upon receipt, store at -20°C or -80°C. Avoid repeated freeze.
-
貨期:Basically, we can dispatch the products out in 1-3 working days after receiving your orders. Delivery time maybe differs from different purchasing way or location, please kindly consult your local distributors for specific delivery time.
-
用途:For Research Use Only. Not for use in diagnostic or therapeutic procedures.
相關(guān)產(chǎn)品
靶點(diǎn)詳情
-
功能:Facilitative glucose transporter, which is responsible for constitutive or basal glucose uptake. Has a very broad substrate specificity; can transport a wide range of aldoses including both pentoses and hexoses. Most important energy carrier of the brain: present at the blood-brain barrier and assures the energy-independent, facilitative transport of glucose into the brain. In association with BSG and NXNL1, promotes retinal cone survival by increasing glucose uptake into photoreceptors.
-
基因功能參考文獻(xiàn):
- SLC2A1 variants and haplotypes may be involved in the pathogenesis of diabetic nephropathy [meta-analysis] PMID: 30353771
- These findings promote development of metabolic-based cancer detection technologies, and suggest that 2GF-GNPs may enable specific cancer detection in a wide range of tumors characterized by high GLUT-1 expression PMID: 30028251
- Kazakh and Han patients with esophageal squamous cell carcinoma with Glut1 c-myc co-expression had poorer prognosis. PMID: 29629851
- miR-328 expression is reduced in colon cancer patients and thus inversely correlates with the classically reported upregulated SLC2A1/GLUT1 expression in tumors. PMID: 29374351
- Glucose transporter-1 could play a role not only in the onset of psoriasis but also in the progression and severity of the disease. It may participate in the pathogenesis of psoriasis through the facilitation of epidermal hyperproliferation, inflammation, and angiogenesis. PMID: 29797802
- Data suggest that GLUT1 functions as tetramer of adjacent dimers of allosteric, alternating access transporters in which (a) cis-allostery is mediated by intra-subunit interaction and (b) trans-allostery requires inter-subunit interaction. Endofacial (vs exofacial) cis-allostery obtains when affinity of un-liganded e1 (endofacial) GLUT1 subunit in one dimer is increased by occupancy of e1 GLUT1 subunit of adjacent dimer. PMID: 29066623
- Results show that GLUT1 is sensitive and specific marker for colorectal cancer (CRC). It is overexpressed in young age patients, poor performance status, and stage IV patients. Although this was not statistically significant, GLUT 1 showed higher expression level in patients with lesser survival. PMID: 29205188
- GLUT1 ectopic overexpression makes PCa cells more resistant to glucose deprivation and oxidative stress-induced cell death. Under glucose deprivation, GLUT1 overexpressing PCa cells sustains mitochondrial SOD2 activity, compromised after glucose removal, and significantly increases reduced glutathione (GSH) PMID: 29684818
- Results confirm the positive expression of Glut1 in colorectal neoplasm (CRC) and its involvement in proliferation and cell survival of cancer cells. Its silencing inhibits the proliferation and promoted apoptosis of CRC cells by inactivating TGF-beta/PI3K-AKT-mTOR signaling pathway. PMID: 28884839
- p-ERK-mediated phosphorylation and stabilization of JMJD2B during glucose deprivation contributes to its role in glucose uptake and cell viability, which may be modulated through epigenetically upregulation of GLUT1 in colon cancer cells. PMID: 28945223
- work characterized the clustering distribution of GLUT1 and linked its spatial structural organization to the functions, which would provide insights into the activation mechanism of the transporter. PMID: 29915035
- This study present the results from the molecular genetics study of the SLC2A1 gene in Bulgarian patients with different forms of genetic generalized epilepsy having emerged in childhood. PMID: 29223885
- Expression of SLC5A5 mRNA was negatively correlated with SLC2A1 mRNA. This finding provides a molecular basis for the management of PTC with negative WBS using F-FDG PET scans. In addition, higher expression of SLC5A5 mRNA was associated with less PTC [papillary thyroid cancer] recurrence, but not with deaths. PMID: 29978611
- GLUT-1 in nasopharyngeal carcinoma and its clinical significance PMID: 29164572
- YAP1 interacted with TEAD1, exerted their transcriptional control of the functional target, glucose transporter 1 (Glut1). PMID: 28892790
- experiments mainly reveal that the CREB1 could affect glucose transport in glioma cells by regulating the expression of GLUT1, which controlled the metabolism of glioma and affected the progression of glioma. PMID: 28646353
- These data provide new insights into the physiological relevance of GLUT1 multimerization as well as a new variant of bioluminescent Forster resonance energy transfer assay that is useful for measuring the interactions among other cell membrane proteins in live cells PMID: 27357903
- Study demonstrated that the high mRNA level of both MCT1 and GLUT1 correlated with poor prognosis, high- Fuhrman grade clear-cell renal cell carcinoma and metabolic reprogramming. PMID: 29481555
- GLUT1 and MCT1 membrane overexpression was significantly higher in Papillary Renal Cell carcinoma PMID: 28028797
- the TT genotype in XbaI G>T SNP and CC genotype of HaeIII T>C SNP may have protective effect in the carcinogenesis process of UCC. In the XbaI G>T SNP, the GG genotype of was positively related to tumor proliferation, glucose metabolism, tumor grade and stage. PMID: 28524154
- HOTAIR promoted glycolysis by upregulating glucose transporter isoform 1 (GLUT1) and activating mammalian target of rapamycin (mTOR) signaling. PMID: 28731193
- In preeclampsia, placental GLUT1 expression and function are down-regulated at the apical plasma membrane of the syncytiotrophoblast. PMID: 28623979
- High glut1 expression is associated with Pancreatic Cancer. PMID: 28180987
- Study confirms the high expression of Glut-1 not only in endometrioid carcinomas but also in other carcinomas of endometrium including clear cell and serous types. Glut-1 expression can be used as a surrogate marker in differential diagnosis between hyperplasia with and without atypia. PMID: 28381136
- This systematic review and meta-analysis indicated that the GLUT1 may serve as an ideal prognostic biomarker in various cancers. PMID: 28498810
- This study did not detect any pathogenic mutations in SLC2A1 in the patient with focal epilepsy. PMID: 28419980
- Taken together, our study provides a new perspective of miR-148b in gastric cancer (GC) development through inhibiting glycolysis in GC cells , directly targeting glucose transporter SLC2A1. PMID: 28440026
- Data suggest that plasma glycation with erythrocyte membrane modification is associated with oxidative stress, GLUT1 expression, and erythrocyte fragility in patients with type 2 diabetes; such glycation may further contribute to progression of diabetic vascular complications. PMID: 27884659
- FOXM1 bound directly to the GLUT1 and HK2 promoter regions and regulated the promoter activities and the expression of the genes at the transcriptional level. This reveals a novel mechanism by which glucose metabolism is regulated by FOXM1. PMID: 27351131
- Whereas, Glut1-mediated glucose uptake also requires mTORC2 phosphorylation of the hydrophobic domain, demonstrating both phosphorylation-dependent and independent roles of the hydrophobic domain in regulating glucose uptake. PMID: 28589878
- The levels of GLUT1 and GLUT3, the major brain glucose transporters, are decreased, especially in the cerebral cortex in patient with Alzheimer disease. PMID: 27858715
- High levels of GLUT1 are associated with Lung Adenocarcinoma. PMID: 29374742
- Glucose transporter type 1 deficiency syndrome is the result of impaired glucose transport into the brain. Patients with glucose transporter type 1 syndrome may present with infantile seizures, developmental delay, acquired microcephaly, spasticity and ataxia. PMID: 28443597
- The results demonstrated the high frequency of C allele of SLC2A1 HaeIII in Kurdish patients with diabetic nephropathy. It was also found that this polymorphism is a significant risk factor for diabetic nephropathy. The effect of this polymorphism on clinical and laboratory characteristics of diabetic nephropathy patients was significant. PMID: 26337659
- Expression of GLUT1 is stimulated by hyperglycemia and low oxygen supply, and this overexpression was associated with increased activity of GLUT1 in the cell membrane that contributes to the impairment of the RPE secretory function of PEDF. PMID: 27440994
- A heterozygous SLC2A1 mutation in the severely affected child was inherited from his less severely affected mother who was mosaic for the mutation PMID: 28124377
- UCP2 stimulates hnRNPA2/B1, GLUT1 and PKM2 expression and sensitizes pancreatic cancer cells to glycolysis inhibition. PMID: 27989750
- ablation of Glut1 attenuated apoptosis and increased drug resistance via upregulation of p-Akt/p-GSK-3beta (Ser9)/beta-catenin/survivin. PMID: 28803837
- Data show that SALL4 promotes the expression of Glut1 and open chromatin through a HP1alpha-dependent mechanism. PMID: 28759035
- Results show that PPARalpha directly targeted the consensus PPRE motif of Glut1 promoter region resulting in Glut1 transcription repression leding to decreased influx of glucose in cancer cells. PMID: 27918085
- Strong GLUT1 staining was inversely associated with circulating levels of fasting glucose in high grade serous ovarian cancer. PMID: 28542798
- Metabolically active CD4+ T cells expressing Glut1 and OX40 preferentially harbor HIV during in vitro infection. PMID: 28892135
- SLC2A1/GLUT1 is expressed late in the adenoma-carcinoma sequence during carcinogenesis in intraductal papillary mucinous neoplasms of the pancreas. PMID: 28412205
- Paraoxonase 2 facilitates pancreatic ductal cancer growth and metastasis by stimulating GLUT1-mediated glucose transport. PMID: 28803777
- Data show that Prima-1 kills hypoxic wt p53 KRAS-mutant cells resistant to 3-bromopyruvate (3-BrPA), partly by decreasing GLUT-1 expression. PMID: 27863474
- A de novo 5'-UTR variant in SLC2A1, generating a novel translation initiation codon, severely compromising SLC2A1 function was identified in a GLUT1 deficiency syndrome patient. PMID: 28378819
- High GLUT1 expression is associated with metastasis and epithelial-mesenchymal transition in hepatocellular carcinoma. PMID: 28429188
- High GLUT-1 expression predicted shorter overall survival (OS) in patients with pancreatic cancer, and was was associated with a tumor size of >2 cm and presence of lymph node metastasis. PMID: 28178665
- detected significantly reduced GLUT1 expression only on red blood cells from patients with GLUT1-Deficiency Syndrome. PMID: 28556183
- GLUT-1(+) specimens were classified as true infantile hemangioma (IH) and GLUT-1(-) specimens were reclassified as pyogenic granulomas and vascular malformations based on their histopathological features. PMID: 28545938
顯示更多
收起更多
-
相關(guān)疾病:GLUT1 deficiency syndrome 1 (GLUT1DS1); GLUT1 deficiency syndrome 2 (GLUT1DS2); Epilepsy, idiopathic generalized 12 (EIG12); Dystonia 9 (DYT9); Stomatin-deficient cryohydrocytosis with neurologic defects (SDCHCN)
-
亞細(xì)胞定位:Cell membrane; Multi-pass membrane protein. Melanosome. Photoreceptor inner segment.
-
蛋白家族:Major facilitator superfamily, Sugar transporter (TC 2.A.1.1) family, Glucose transporter subfamily
-
組織特異性:Detected in erythrocytes (at protein level). Expressed at variable levels in many human tissues.
-
數(shù)據(jù)庫(kù)鏈接:
Most popular with customers
-
-
YWHAB Recombinant Monoclonal Antibody
Applications: ELISA, WB, IHC, IF, FC
Species Reactivity: Human, Mouse, Rat
-
Phospho-YAP1 (S127) Recombinant Monoclonal Antibody
Applications: ELISA, WB, IHC
Species Reactivity: Human
-
-
-
-
-